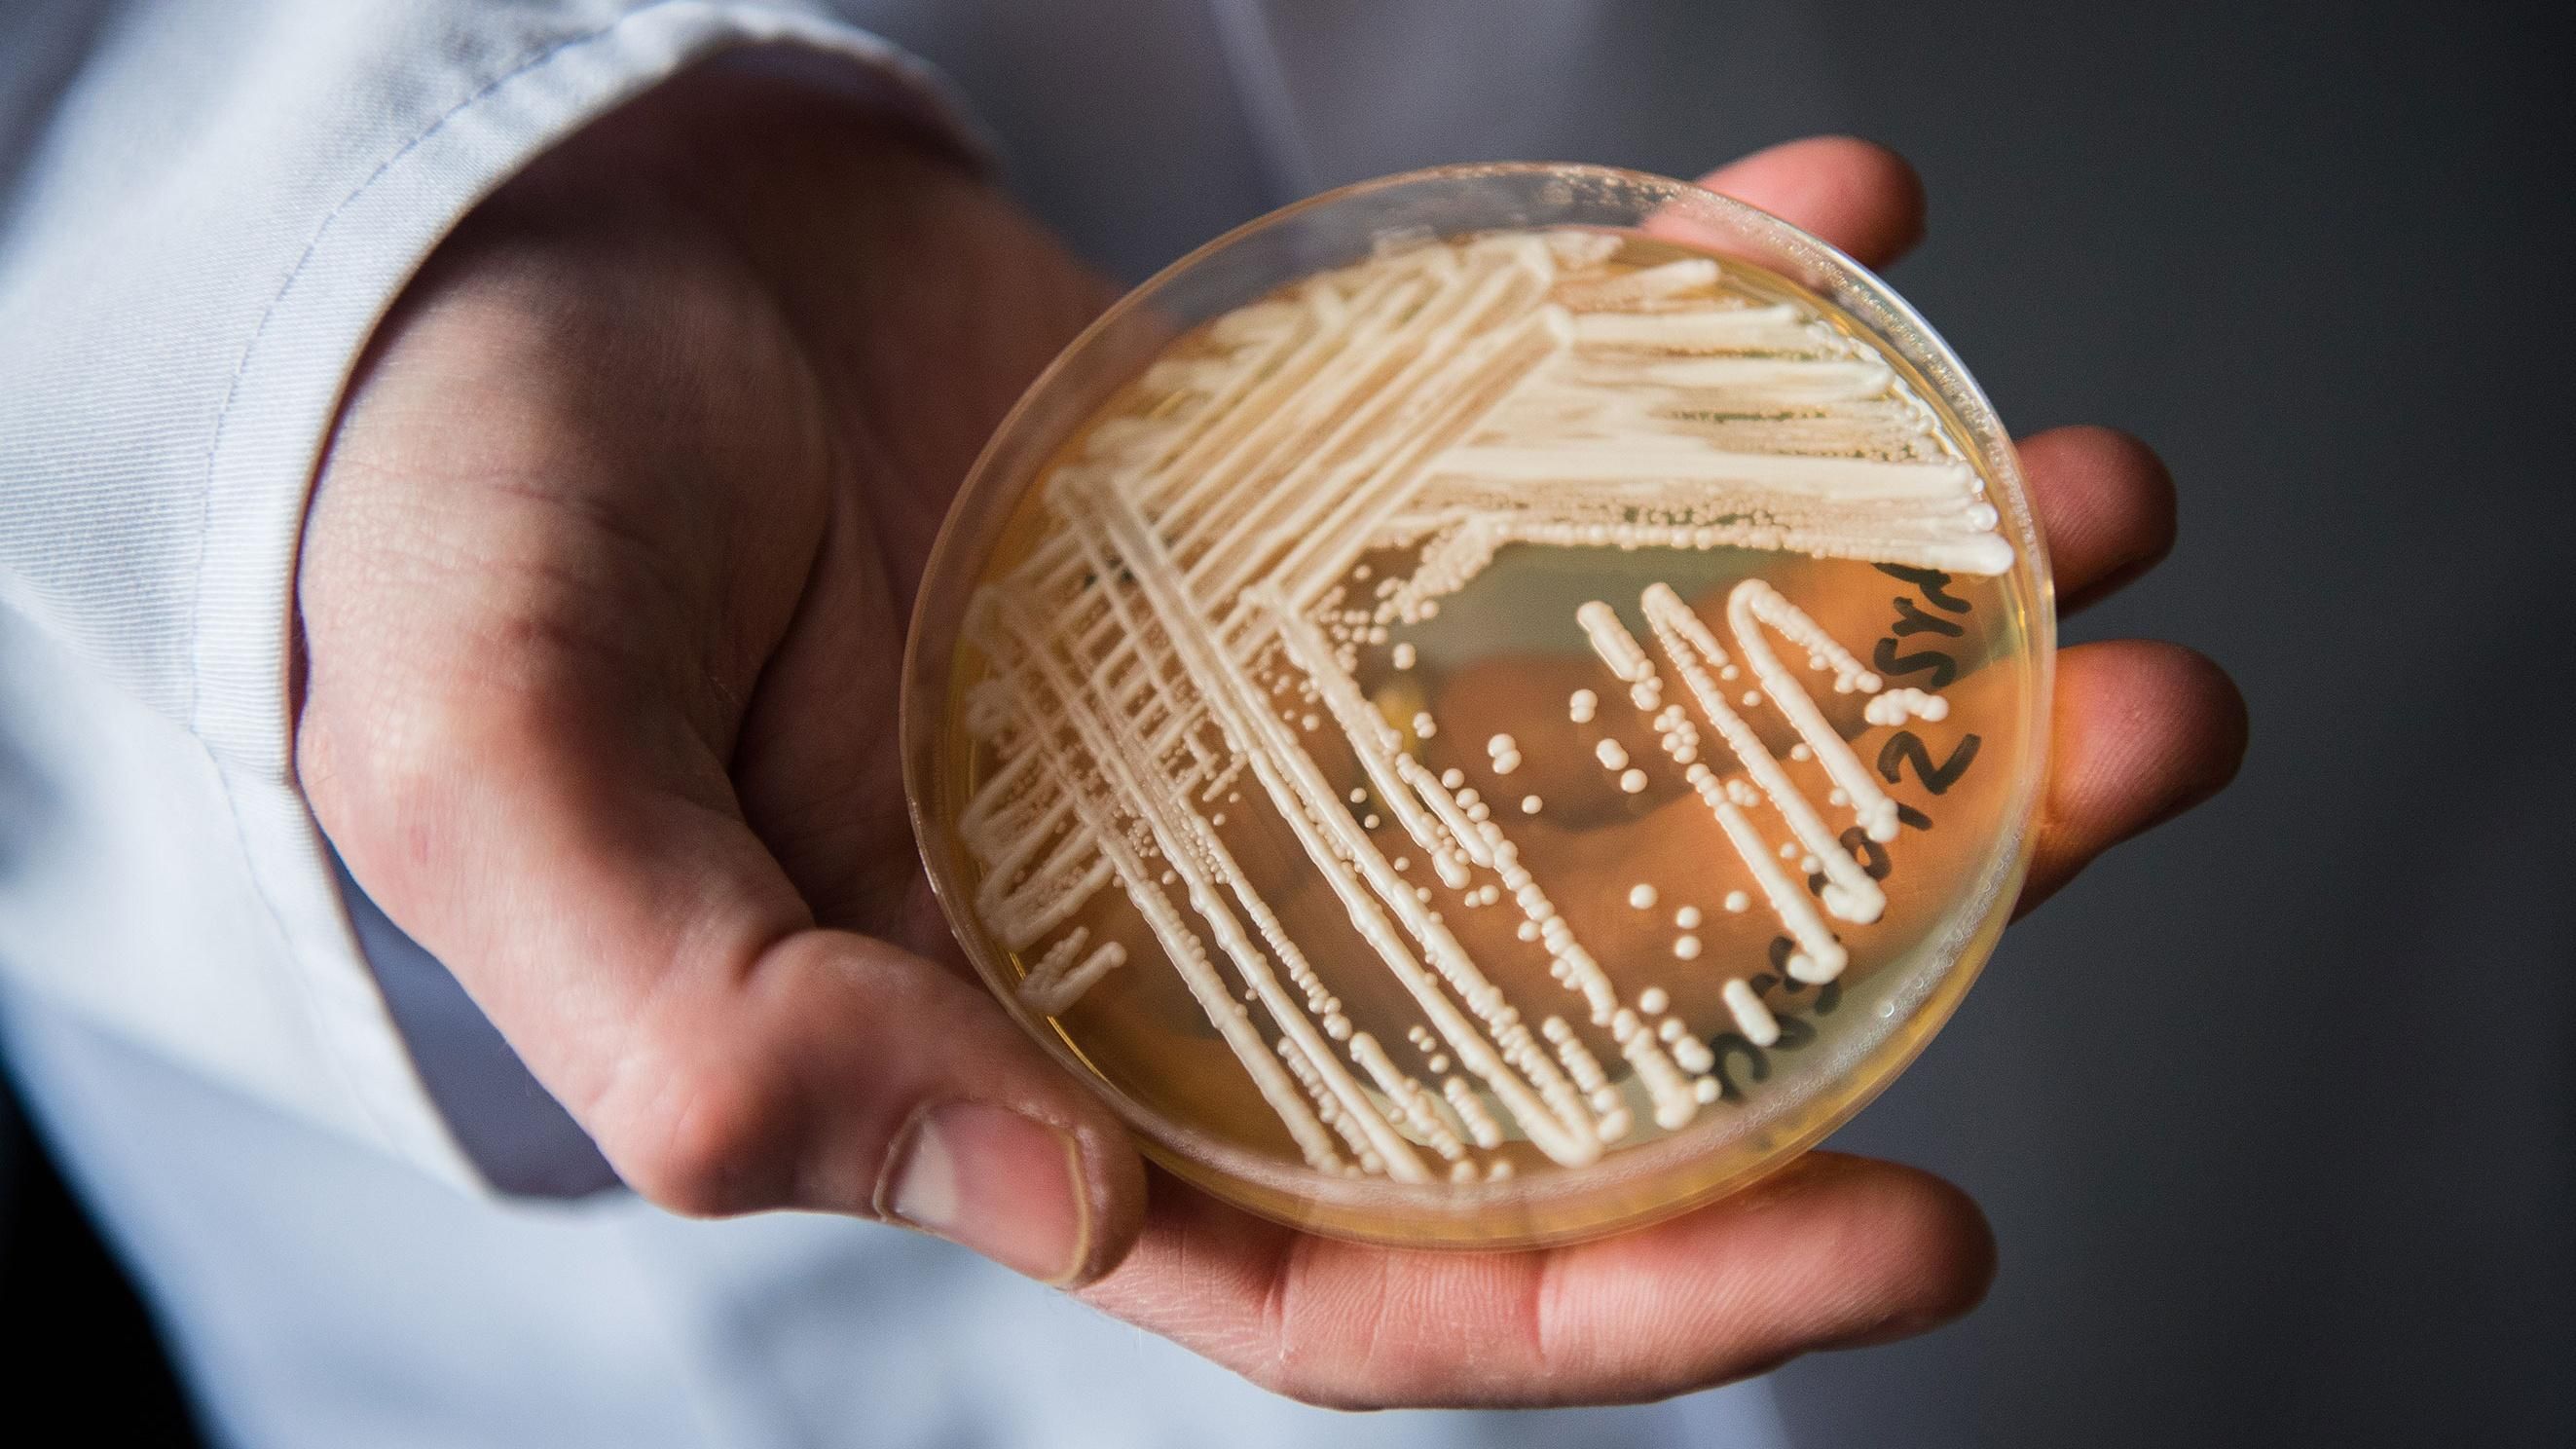
Новий супергрібок Candida auris: небезпека нового супергрібка для людей Новий супергрібок Candida auris: небезпека нового супергрібка для людей

За словами міжнародної групи вчених, це відбувається через глобальне потепління, пише журнал mBio.
Читайте також: З початку року більше сотні дітей захворіли на небезпечну хворобу
Це може привести до того, що головний природний захист людини проти грибів – постійно висока температура тіла – перестане діяти. Ймовірно, що Candida auris почала інфікувати людей через підвищення температури на планеті.
Гриби рідко вражають теплокровних тварин. Все тому, що при температурі 37–42 градусів Цельсія вони складно розмножуються та ростуть. Тому грибкові інфекції спостерігаються у людей у найменш теплих частинах тіла, а у внутрішніх органах лише у тих людей, чим імунітет ослаблений.
Після проникнення у кров гриби викликають у людей інфекції з летальним результатом в 60% випадків. Найчастіше ним заражаються в лікарнях, де мешкають найбільш стійкі до ліків збудники захворювань. C. auris – це єдиний гриб, для якого відомі стійкі до всіх штампів протигрибкові засоби.
Дослідники порівняли стійкість до високих температур у Candida auris і декількох десятків інших видів грибів, що є з C.auris в родинному зв'язку різного ступеня.
Еволюція C.auris посприяла виживанню грибка у рідинах тіла людини
Виявили, що еволюція C.auris посприяла виживанню грибка у рідинах тіла людини.
Першими жертвами грибка могли стати навколоводні види птахів. Вони нерідко мігрують і вступають в контакт з домашньою птицею. Від качок і курей інфекція могла передатися фермерам, а коли ті їздили в міста отримувати медичну допомогу, вони привозили з собою в лікарні патогенний гриб.
Адаптація Candida auris до гарячої солонуватої води (наближеної до неї можна вважати й людську кров) триває. Це означає, що незабаром теплокровність людей перестане бути для цього грибка перешкодою.
Більше новин, що стосуються лікування, медицини, харчування, здорового способу життя та багато іншого – читайте у розділі Здоров'я.